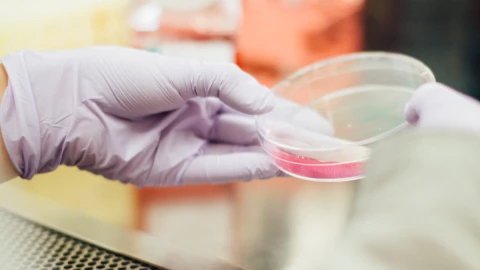
prueba_adn_primos.jpg

Una joven buscaba conocer más acerca de sus orígenes y se llevó una sorpresa al descubrir por una prueba de ADN que salía con alguien de su propia familia.
Se trata de Matilda, una mujer que compartió en su cuenta de TikTok la historia de cómo se enteró que su entonces novio era en realidad su primo.
Te puede interesar: Segunda vuelta electoral en Perú será en junio 6
Matilda relató que es adoptada y no conocía a su padre biológico, por lo que su novio compró unas pruebas de ADN para que ella pudiera saber más sobre sus raíces y aprovechó la oferta para aplicarse una también.
Ambos se realizaron la prueba de ADN y en un mes, es decir, en septiembre pasado, recibieron los resultados donde Matilda encontró que entre sus familiares había alguien que se llamaba igual que su novio.
Te puede interesar: Brasil es un barril de pólvora y está al límite: Bolsonaro
“Esto es bastante raro, soy pariente de alguien que tiene el mismo nombre que tú”, le dijo la joven a su entonces novio, por lo que al indagar, encontró que su pareja era su primo en segundo grado.
“Y así fue cómo descubrí que mi pareja era, en realidad, mi primo”, dijo Matilda a través de la plataforma TikTok.
Te puede interesar: Sputnik V: 94% de los vacunados generan anticuerpos con una dosis
El lugar en donde se realizaron la prueba de ADN les informó que probablemente eran primos terceros porque comparten bisabuelos, pero la joven cree que más bien son primos segundos.
A esta conclusión llegó porque, al investigar más a profundidad la familia de su padre biológico, descubrió que había “demasiado” ADN en común para ser primos en tercer grado.
Pese a este incidente, la pareja continuó los siguientes cuatro meses después de enterarse que eran primos y después terminaron su relación por problemas diversos, que aseguró la joven, no tenían nada que ver con ser familia.
Te puede interesar: VIDEO: Maestra grita a sus alumnos en clase en línea y la suspenden